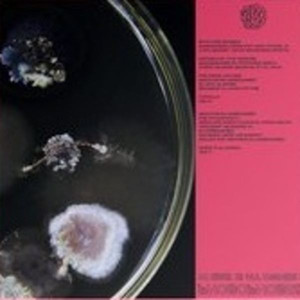

Свалка дисков
Артикул: CDVP 3390388
EAN: 0826853964616
Состав: 1 LP
Состояние: Новое. Заводская упаковка.
Дата релиза: 01-01-2017
Артикул: CDVP 3390370
EAN: 4260038318843
Состав: 1 LP
Состояние: Новое. Заводская упаковка.
Артикул: CDVP 3390358
EAN: 4571179538329
Состав: 1 LP
Состояние: Новое. Заводская упаковка.
Дата релиза: 01-01-2017
Артикул: CDVP 3390328
EAN: 4571179538367
Состав: 1 LP
Состояние: Новое. Заводская упаковка.
Дата релиза: 01-01-2017
Артикул: CDVP 3390327
EAN: 0897819009023
Состав: 1 CD
Состояние: Новое. Заводская упаковка.
Дата релиза: 01-01-2017
Артикул: CDVP 3390298
EAN: 4571179530361
Состав: 1 LP
Состояние: Новое. Заводская упаковка.
Артикул: CDVP 3390297
EAN: 0780163510027
Состав: 2 LP
Состояние: Новое. Заводская упаковка.
Артикул: CDVP 3390288
EAN: 0604862201126
Состав: 1 CD
Состояние: Новое. Заводская упаковка.
Артикул: CDVP 3390273
EAN: 5060146097970
Состав: 1 Audio Cassette
Состояние: Новое. Заводская упаковка.
Дата релиза: 19-01-2018
Артикул: CDVP 3390234
EAN: 0725543604910
Состав: 1 LP
Состояние: Новое. Заводская упаковка.
Артикул: CDVP 3390231
EAN: 4571179530323
Состав: 1 LP
Состояние: Новое. Заводская упаковка.
Дата релиза: 01-01-2017
Артикул: CDVP 3390225
EAN: 4571179530347
Состав: 1 LP
Состояние: Новое. Заводская упаковка.
Артикул: CDVP 3390185
EAN: 4260038318850
Состав: 1 LP
Состояние: Новое. Заводская упаковка.
Дата релиза: 01-01-2017
Артикул: CDVP 3390152
EAN: 0781484067542
Состав: 1 Audio Cassette
Состояние: Новое. Заводская упаковка.
Дата релиза: 01-01-2017
Артикул: CDVP 3390132
EAN: 0752617007926
Состав: 1 CD
Состояние: Новое. Заводская упаковка.
Дата релиза: 01-01-2017
Артикул: CDVP 3390129
EAN: 4571179530316
Состав: 1 LP
Состояние: Новое. Заводская упаковка.
Дата релиза: 01-01-2017
Артикул: CDVP 3390112
EAN: 4260544821967
Состав: 1 LP
Состояние: Новое. Заводская упаковка.
Дата релиза: 01-01-2017
Артикул: CDVP 3390063
EAN: 5053760034117
Состав: 1 LP
Состояние: Новое. Заводская упаковка.
Дата релиза: 01-01-2016
Артикул: CDVP 3390058
EAN: 5050580683457
Состав: 1 LP
Состояние: Новое. Заводская упаковка.
Дата релиза: 01-01-2017
Артикул: CDVP 3390023
EAN: 0897819009030
Состав: 1 CD
Состояние: Новое. Заводская упаковка.
Артикул: CDVP 3389983
EAN: 4571179530378
Состав: 1 LP
Состояние: Новое. Заводская упаковка.
Дата релиза: 01-01-2017
Артикул: CDVP 3389945
EAN: 5060249910237
Состав: 1 Automotive
Состояние: Новое. Заводская упаковка.
Артикул: CDVP 3389938
EAN: 0881034196262
Состав: 1 Audio Cassette
Состояние: Новое. Заводская упаковка.
Дата релиза: 26-01-2018
Артикул: CDVP 3389901
EAN: 0897819009108
Состав: 1 CD
Состояние: Новое. Заводская упаковка.
Дата релиза: 01-01-2017
Артикул: CDVP 3389862
EAN: 0097037184230
Состав: 1 CD
Состояние: Новое. Заводская упаковка.
Дата релиза: 01-01-2017
Артикул: CDVP 3389819
EAN: 0769791968424
Состав: 1 CD
Состояние: Новое. Заводская упаковка.
Артикул: CDVP 3577258
EAN: 0600753537879
Состав: 1 CD
Состояние: Новое. Заводская упаковка.
Дата релиза: 01-01-2014
Лейбл: Universal Music Group International (UMGI)